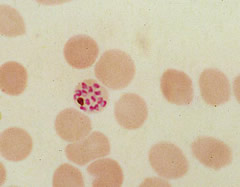

Un equipo internacional de científicos ha descubierto que el parásito transmisor de la malaria Plasmodium knowlesi, que previamente sólo se había detectado en monos, se ha propagado entre humanos. La infección emergente, transmitida principalmente por las hembras del mosquito Anopheles, puede ser mortal si no se diagnostica y trata rápidamente.
Plasmodium knowlesi
La malaria, que mata a más de un millón de personas cada año, es causada por la picadura de mosquitos infectados con parásitos, los Plasmodium.
Imagen: P. falciparum (W. Commons) |
Las cuatro especies de parásitos Plasmodium que comúnmente causan la enfermedad en humanos son el Plasmodium falciparum - más común en África- es el más mortal, Plasmodium vivax, Plasmodium ovale y
Plasmodium malariae -que se encuentra en regiones tropicales y subtropicales en todo el mundo y provoca síntomas que son a menudo menos graves.
Ahora, sin embargo, un equipo internacional de científicos en la Universidad de Malasia Sarawak, ha realizado un estudio, publicado en la revista Clinical Infectious Diseases, en el que han descubierto la propagación del Plasmodium knowlesi, que previamente sólo se había encontrado en monos, entre humanos, causando una infección tan mortal como el Plasmodium falciparum.
Aunque la nueva infección hasta ahora sólo se ha concentrado en el sureste de Asia, los científicos advierten que, con el turismo en la región, pronto podrían empezar a haber también casos en países de occidente.
Reproducción rápida del parásito
Uno de los problemas que plantea esta nueva infección es que los parásitos P.knowlesi y P. malariae son
Imagen: P. knowlesi (CDC) |
muy similares bajo el microscopio y pueden confundirse fácilmente. "Sin embargo el P. malariae causa una forma benigna de malaria. En cambio, debido a que los parásitos knowlesi se reproducen cada 24 horas en la sangre, la enfermedad puede ser potencialmente fatal, siendo esenciales tanto el diagnóstico temprano como el tratamiento apropiado" afirma el profesor Balbir Singh, que dirigió la investigación.
Los investigadores llevaron a cabo pruebas en más de 150 pacientes internados en el hospital en Sarawak, en el Borneo de Malasia, entre julio de 2006 y enero de 2008, con infección de malaria y descubrieron que el P. knowlesi estaba en más de 65% de las infecciones, lo que resulta un amplio espectro de la enfermedad.
Tasa de mortalidad
La mayoría de los casos de infección no eran complicados, dicen los autores, y pudieron ser tratados fácilmente con medicamentos, como la cloroquina y la primaquina. Sin embargo, uno de cada 10 pacientes desarrolló complicaciones, como dificultades para respirar y problemas de riñón, y dos murieron.
Tal como señalan los investigadores, aunque la tasa de mortalidad fué de menos de 2%, el P. knowlesi es una infección tan mortal como el P. falciparum y subrayan que dado el pequeño número de casos que han sido estudiados hasta ahora es difícil determinar una tasa precisa de fatalidad.
En el estudio, todos los pacientes afectados por el P. knowlesi mostraron un bajo nivel de plaquetas en la sangre, significativamente más bajo que el que normalmente se encuentra en otros tipos de malaria y los científicos creen que el bajo conteo de plaquetas en la sangre podría ser utilizado como una forma potencial de diagnóstico de la infección del P. knowlesi.
Riesgo de expansión a países occidentales
El profesor Singh subraya que es importante estar alerta para la detección de nuevos casos en otras regiones del mundo. "El aumento en el turismo en el sureste de Asia podría significar que aumenten los casos en el futuro, y esto incluye a los países occidentales".
"Los médicos que revisen a un paciente que haya visitado una zona con una conocida transmisión de P. knowlesi deben estar conscientes del diagnóstico, las manifestaciones clínicas y el rápido y potencialmente grave avance de la este tipo de malaria", añadió el investigador.
Fuente: BBC
Foto cabecera: P.malariae (CDC)